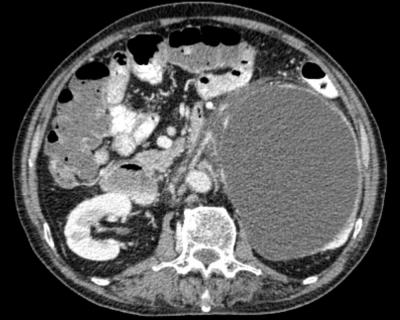

-
SHIFT-MTERMS 2024
splenic hilar mass with carcinoid symptom

abdominal mass with haematuria
Biliary & Gastric Dilation

Left Facial Tumour. What Is It?

On the Occasion of 10th Anniversary
Vein of Galen Malformation
Vein of Galen Malformation
Pharmacovigilance and Reporting Adverse Drug Reactions
The History of RNAi and MicroRNA Discovery
